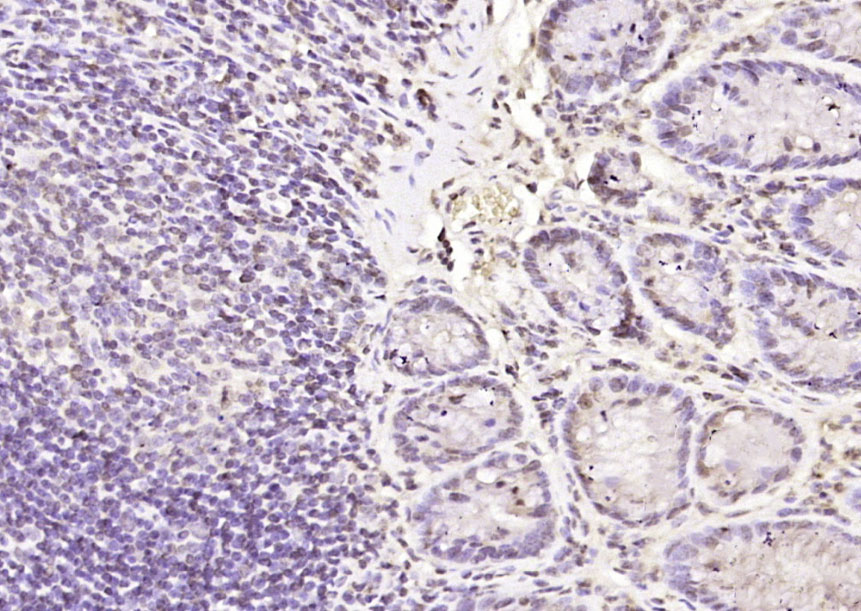
产品细节图片3

相关产品推荐更多 >

SLC34A1 Rabbit pAb, BF405 conjugated(bs-19812R-BF405)-100ul
¥2980
GADD45B Rabbit pAb, PerCP-Cy7 conjugated(bs-5904R-PerCP-Cy7)-100ul
¥2980
TRPC6 Rabbit pAb, BF405 conjugated(bs-2393R-BF405)-100ul
¥2980
PTGER2 Rabbit pAb(bs-4196R)-50ul/100ul/200ul
¥1180
phospho-HER2 (Tyr1221) Rabbit pAb, PE conjugated(bs-13090R-PE)-100ul
¥2980
万千商家帮你免费找货
0 人在求购买到急需产品
- 详细信息
- 技术资料
- 应用范围:
产品信息以Bioss网站为准
- 规格:
50ul/100ul/200ul
| 规格: | 50ul | 产品价格: | ¥1180.0 |
|---|---|---|---|
| 规格: | 100ul | 产品价格: | ¥1980.0 |
| 规格: | 200ul | 产品价格: | ¥2800.0 |
| 产品编号 | bs-10377R |
| 英文名称 | Galectin 3 Rabbit pAb |
| 中文名称 | 半乳糖凝集素3抗体 |
| 英文别名 | LEG3_HUMAN; Galectin-3; LGALS3; Gal-3; 35 kDa lectin; Carbohydrate-binding protein 35; CBP 35; CBP35; Galactose-specific lectin 3; Galactoside-binding protein ; GALBP; IgE-binding protein; L-31; Laminin-binding protein; Lectin L-29; Mac-2 antigen; MAC2; galectin 3; L31; GAL3; GALIG; |
| 产品应用 | IHC-P=1:100-500, IHC-F=1:100-500, IF=1:100-500 Not yet tested in other applications. |
| 交叉反应 | Mouse, Rat |
| 抗体来源 | Rabbit |
| 免疫原 | KLH conjugated synthetic peptide derived from mouse Galectin-3 |
| 亚型 | IgG |
| 性状 | Liquid |
| 纯化方法 | affinity purified by Protein A |
| 克隆类型 | Polyclonal |
| 理论分子量 | 29 kDa |
| 浓度 | 1mg/ml |
| 储存液 | 0.01M TBS (pH7.4) with 1% BSA, 0.02% Proclin300 and 50% Glycerol. |
| 研究领域 | Cell Biology > Cell Cycle > Cell differentiation Neuroscience > Cell Adhesion Proteins > Nuclear Proteins |
| 亚基 | Probably forms homo- or heterodimers. Interacts with DMBT1 (By similarity). Forms a complex with the ITGA3, ITGB1 and CSPG4. Interacts with LGALS3BP, LYPD3, CYHR1 and UACA. |
| 亚细胞定位 | Cytoplasm. Nucleus. Secreted. Note=Secreted by a non-classical secretory pathway and associates with the cell surface. |
| 组织特异性 | A major expression is found in the colonic epithelium. It is also abundant in the activated macrophages. |
| 相似性 | Contains 1 galectin domain. |
| 功能 | Galactose-specific lectin which binds IgE. May mediate with the alpha-3, beta-1 integrin the stimulation by CSPG4 of endothelial cells migration. Together with DMBT1, required for terminal differentiation of columnar epithelial cells during early embryogenesis. In the nucleus: acts as a pre-mRNA splicing factor. Involved in acute inflammatory responses including neutrophil activation and adhesion, chemoattraction of monocytes macrophages, opsonization of apoptotic neutrophils, and activation of mast cells. |
| 保存条件 | Shipped at 4℃. Store at -20℃ for one year. Avoid repeated freeze/thaw cycles. |
| 注意事项 | This product as supplied is intended for research use only, not for use in human, therapeutic or diagnostic applications. |
| 背景资料 | This gene encodes a member of the galectin family of carbohydrate binding proteins. Members of this protein family have an affinity for beta-galactosides. The encoded protein is characterized by an N-terminal proline-rich tandem repeat domain and a single C-terminal carbohydrate recognition domain. This protein can self-associate through the N-terminal domain allowing it to bind to multivalent saccharide ligands. This protein localizes to the extracellular matrix, the cytoplasm and the nucleus. This protein plays a role in numerous cellular functions including apoptosis, innate immunity, cell adhesion and T-cell regulation. The protein exhibits antimicrobial activity against bacteria and fungi. Alternate splicing results in multiple transcript variants.[provided by RefSeq, Oct 2014] |
| 应用 | 推荐稀释比例 |
| {IHC-P} | {1:100-500} |
| {IHC-F} | {1:100-500} |
| {IF} | {1:100-500} |

Antigen retrieval: citrate buffer ( 0.01M, pH 6.0 ), Boiling bathing for 15min; Block endogenous peroxidase by 3% Hydrogen peroxide for 30min; Blocking buffer (normal goat serum,C-0005) at 37℃ for 20 min;
Incubation: Anti-Galectin-3 Polyclonal Antibody, Unconjugated(bs-10377R) 1:500, overnight at 4°C, followed by conjugation to the secondary antibody(SP-0023) and DAB(C-0010) staining

Antigen retrieval: citrate buffer ( 0.01M, pH 6.0 ), Boiling bathing for 15min; Block endogenous peroxidase by 3% Hydrogen peroxide for 30min; Blocking buffer (normal goat serum,C-0005) at 37℃ for 20 min;
Incubation: Anti-Galectin-3 Polyclonal Antibody, Unconjugated(bs-10377R) 1:500, overnight at 4°C, followed by conjugation to the secondary antibody(SP-0023) and DAB(C-0010) staining
风险提示:丁香通仅作为第三方平台,为商家信息发布提供平台空间。用户咨询产品时请注意保护个人信息及财产安全,合理判断,谨慎选购商品,商家和用户对交易行为负责。对于医疗器械类产品,请先查证核实企业经营资质和医疗器械产品注册证情况。
技术资料暂无技术资料 索取技术资料





